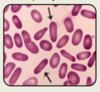

Haemoglobinopathies Flashcards
why might anaemia develop
1) Problems with blood cell formation in bone marrow
2) Problem with peripheral blood cells
3) Removal of RBC
1) Problems with blood cell formation in bone marrow
- Reduced or dysfunctional erythropoiesis
- Abnormal haem synthesis
- Abnormal globin chain synthesis
2) Problem with peripheral blood cells
- Abnormal structure
- Mechanical damage
- Abnormal metabolism
- Excessive bleeding
3) Removal of RBC
Increased removal by reticuloendothelial system
differ Hb expressed during
development as ana daptive resposnse to variation in oxygen requirments
embryonic forms
- HbF= main form before birth
- hbA commnces before birth and steadily increases to become dominant after birth

major Hb types in adults
usually 2alpha and 2 beta

Structure of haemoglobin
Haemoglobin (Hb) is a globular protein composed of four protein chains (tetramer).
These four chains are made up of 2α paired with 2 other chain types
Attached to each of globin chain is an iron (Fe2+) ion which allows for oxygen bonding.
HbA
2α/2β
HbA2
2α/2ẟ
HbF
2α/2γ
what are haemoglobinopathies
- are genetic disorders (usually autosomal recessive) that alter the structure of haemoglobin.
- This may result:
- in deformed structures
- reduced production of particular globin chains – called thalassaemias
- This results in reduced oxygen carrying capacity of the blood, and produces symptoms of anaemia
reduced or absent expression of structurally normal chain
thalassaemia
abnormality of the chains themselves
sickle cell
how many alpha globin genes
- 2 on maternal chromosomes 16
- 2 on paternal chromosome 16
how many B globin genes
2- 1 one ach chromsosome 11
the globin gene clusters

Thalassaemia
Thalassaemias are autosomal recessive, inherited diseases resulting from the reduced rate of synthesis of normal α- or β- globin chains.
Blood smear for thalassaemia
This results in a lower level of intracellular haemoglobin which causes hypochromic, microcytic red cells seen in patients with thalassaemia.
-
Anisopoikilocytosis with frequent target cells (arrow) and circulating nucleated red blood (arrow head) cells and heinz bodies
- RBC are not usually nucleated- high production

hyperspenism and thalassaemia
In a patient with thalassaemia, the spleen breaks down abnormal RBCs and the iron from the cells is retained rather than being reused.
This excess iron causes hypersplenism, causing the spleen to break down more RBC and lowering haemoglobin levels even further – a splenectomy (removal of the spleen) is frequently performed.
thalassaemia is most prevalent in
- South Asian
- Mediterranean
- Middle east (beta thal)
- Far eat (alpha thal)
Alpha chains
Humans have 4 alpha-globin genes
- 2 found on maternal chromosome 16
- 2 found on paternal chromosome 16
Alpha-Thalassaemia
α-thalassaemias are caused by mutations (usually deletions) in the HBA1 and/or HBA2 genes on chromosome 16. The increased deletion of α chains means there are an excess of β chains in adults, and γ chains in foetuses. This means the patient is unable to form the normal globular proteins in the pattern of 2α and 2 other. The relative excess of these other chains leads to defective red cells, which are destroyed in large numbers by the spleen – this causes haemolytic anaemia.